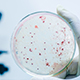

Welcome to the Gill Lab

Our laboratory studies bacterial pathogens and diseases associated with the human microbiome. Active projects in our laboratory (are described in detail on our projects page) fall under two broad categories:
- Human microbiome communities
- Pathogenesis and genomics of bacterial pathogens

Steven R. Gill, Ph.D.
Principal Investigator
- Early-life gut microbiome composition and rotavirus vaccine-induced IgA responses in U.S. infants: a longitudinal cohort study.; EBioMedicine; Vol 129, pp. 106360. 2026 Jun 30.
- RSV-NTHi Co-Infection Skews Host Immunity by Suppressing Type I IFN Responses and Enhancing Pro-Inflammatory Responses.; Pathogens (Basel, Switzerland); Vol 15(3). 2026 Feb 24.
- Nasal Biomarkers of Acute Illness Severity and Predictors of Recurrent Wheeze in Respiratory Syncytial Virus (RSV) Infected Infants.; The Journal of infectious diseases. 2026 Jan 23.
News
Affiliations
- Microbiology & Immunology
- Environmental Medicine and Public Heath Sciences
- Center for AIDS Research
- Center for Biomedical Informatics
- NIH T32 Training Grant in Cellular, Biochemical & Molecular Sciences
- NIH T32 Training Grant in Immunology
- Immunology, Microbiology, and Virology Ph.D. Program
- Translational Biomedical Science Ph.D. Program
- Center for Tumor Immunology Research
- Genomics Research Center (GRC)
October 31, 2018
Using the Microbiome to Help Premature Babies Grow
April 19, 2018
The Bugs in Your Gut Could Make You Weak in the Knees
November 6, 2017
URMC Awarded Nearly $6 Million to Study Deadly Bone Infections
October 13, 2016
Thomas Mariani Authors Study on Infant Nose, Lung Cells
Contact Us
Gill Lab
601 Elmwood Ave
Rochester, NY 14642